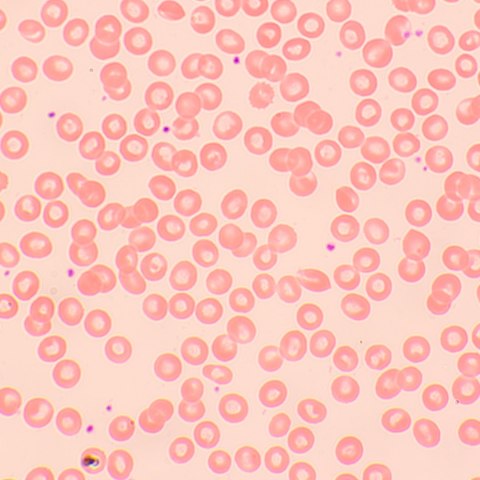

Mikroskop MAGUS Bio 250TL służy do badania cienkich wycinków i rozmazów preparatów biologicznych. Obserwacje mikroskopowe są prowadzone techniką jasnego pola w świetle przechodzącym. Źródłem oświetlenia jest lampa LED 3 W, a układ optyczny obejmuje obiektywy planarno-achromatyczne z korekcją do nieskończoności. Do mikroskopu można dołączyć dodatkowe akcesoria, takie jak urządzenia do ciemnego pola, polaryzacji i kontrastu fazowego. Mikroskop doskonale sprawdza się w analizie laboratoryjnej, badaniach naukowych i edukacji.
Układ optyczny
Głowica trójokularowa zawiera dwie tuby okularów do obserwacji i pionową tubę do mocowania kamery cyfrowej (sprzedawanej oddzielnie). Tuby są pochylone pod kątem 30°, co zwiększa komfort podczas długotrwałych obserwacji. Można je obracać o 360° w celu dostosowania do wzrostu użytkownika. Na lewej tubie umieszczono pierścień regulacji dioptrii.
Obiektywy są zamocowane w misce rewolwerowej z 5 gniazdami - cztery obiektywy są w zestawie, a jedno gniazdo na dodatkowy obiektyw jest wolne. W wolnym gnieździe można umieścić dodatkowy obiektyw, który zwiększy zakres powiększenia. Obiektyw można umieścić na ścieżce optycznej podczas obserwacji, ponieważ miska rewolwerowa jest zwrócona do wewnątrz. Dzięki temu przestrzeń nad stolikiem jest wolna.
Zakres powiększenia wynosi od 40 do 1000 razy (dotyczy konfiguracji podstawowej). Po dodaniu obiektywów zakres powiększenia zwiększy się.
Oświetlenie
Lampa LED jest umieszczona u dołu mikroskopu i zapewnia jasne i równomierne oświetlenie obiektu. Barwa oświetlenia nie zmienia się przy zmianie jasności. Moc oświetlenia wynosi 3 W. Żywotność lampy to 50 000 godzin. Układ oświetlenia ma zasilanie sieciowe.
Regulując pozycję kondensora Abbego i otwierając lub zamykając przysłony polową i aperturową, można ustawić oświetlenie Köhlera. Można również skorzystać z suwaka, aby zastosować technikę ciemnego pola lub kontrastu fazowego (specjalne gniazdo na kondensorze). Suwak znacznie przyspiesza zmianę technik badania.
Stolik i mechanizm regulacji ostrości
Stolik nie ma mechanizmu zapadkowego pozycjonowania osi. Dzięki temu nie zaburza obserwacji, a sam mikroskop zajmuje mniej miejsca na biurku. Mocowanie mechaniczne, które przesuwa preparat, można usunąć (np. w celu ręcznego skanowania).
Do regulowania ostrości służą pokrętła regulacji zgrubnej i precyzyjnej. Pokrętła są umieszczone po obu stronach mikroskopu. Są umieszczone bliżej podstawy, dlatego ich obsługa nie wymaga unoszenia dłoni podczas pracy. Można oprzeć je na stole. Pokrętło zgrubnej regulacji ostrości ma pokrętło blokady i regulację napięcia. Regulacja ostrości jest łatwa i płynna.
Akcesoria
Możliwości mikroskopu MAGUS Bio 250TL można zwiększyć za pomocą asortymentu akcesoriów, które obejmują okulary, obiektywy, preparaty kalibracyjne, kamery cyfrowe oraz urządzenia do ciemnego pola, polaryzacji i kontrastu fazowego.
Najważniejsze właściwości:
- Głowica trójokularowa, miska rewolwerowa na 5 obiektywów, układ optyczny planarno-achromatyczny z korekcją do nieskończoności
- Tuby okularów można obracać o 360°, co ułatwia regulację o dostosowanie do wzrostu użytkownika
- Na lewej tubie umieszczono pierścień regulacji dioptrii; zgrubna i precyzyjna regulacja ostrości
- Pokrętło zgrubnej regulacji ostrości ma pokrętło blokady i regulację napięcia
- Kondensor Abbego ma regulację centralną i regulację wysokości, a przysłony polowa i aperturowa umożliwiają ustawienie oświetlenia Köhlera
- Źródło światła przechodzącego - lampa LED 3 W z regulowaną jasnością, zasilanie 220 V
- Możliwość zamontowania dodatkowych akcesoriów
Zawartość zestawu:
- Podstawa z gniazdem zasilania, źródło światła przechodzącego, mechanizm regulacji ostrości, stolik, uchwyt kondensoraoraz miska rewolwerowa
- Kondensor Abbego
- Głowica trójokularowa
- Obiektyw planarno-achromatyczny z korekcją do nieskończoności: 4x/0,10
- Obiektyw planarno-achromatyczny z korekcją do nieskończoności: 10x/0,25
- Obiektyw planarno-achromatyczny z korekcją do nieskończoności: 40x/0,65 (z mechanizmem sprężynowym)
- Obiektyw planarno-achromatyczny z korekcją do nieskończoności: 100x/1,25 olejowy (z mechanizmem sprężynowym)
- Okular 10x/22 mm z dużym odstępem źrenicy wyjściowej (2 szt.)
- Muszla oczna (2 szt.)
- Filtr (4 szt.)
- Przystawka do smartfonu z montażem typu C
- Pojemnik z olejkiem immersyjnym
- Przewód zasilający
- Osłona przeciwkurzowa
- Instrukcja obsługi i karta gwarancyjna
Dostępne na zamówienie:
- Okular 10x/22 mm ze skalą
- Okular 12,5x/14 mm (2 szt.)
- Okular 15x/15 mm (2 szt.)
- Okular 20x/12 mm (2 szt.)
- Okular 25x/9 mm (2 szt.)
- Obiektyw planarno-achromatyczny z korekcją do nieskończoności: 20x/0,40
- Obiektyw planarno-achromatyczny z korekcją do nieskończoności: 60x/0,80 (z mechanizmem sprężynowym)
- Urządzenie kontrastowo-fazowe
- Suwak kontrastu fazowego
- Kondensor ciemnego pola NA 0,9
- Kondensor ciemnego pola NA 1,36-1,25 do obserwacji z olejkiem immersyjnym
- Suwak ciemnego pola
- Urządzenia do polaryzacji
- Kamera cyfrowa
- Preparat kalibracyjny
- Ekran LCD
<table><tbody><tr><td>Marka</td><td>MAGUS</td></tr><tr><td>Gwarancja, lata</td><td>5</td></tr><tr><td>EAN</td><td>5905555018058</td></tr><tr><td>Rozmiar opakowania (dł. x szer. x gł.), cm</td><td>43.1x27.1x63</td></tr><tr><td>Masa przesyłki, kg</td><td>10.5</td></tr><tr><td>Typ</td><td>biologiczny, lekki/optyczny</td></tr><tr><td>Głowica</td><td>trójokularowa</td></tr><tr><td>Kąt nachylenia głowicy</td><td>30 °</td></tr><tr><td>Powiększenie, x</td><td>40-1000 w konfiguracji podstawowej (*opcjonalnie: 40-1200/1250/1500/1600/2000/2500)</td></tr><tr><td>Powiększenie</td><td>od 800x do 1280x</td></tr><tr><td>Średnica tubusu okularu, mm</td><td>30</td></tr><tr><td>Okulary</td><td>10x/22 mm, odstęp źrenicy wyjściowej: 10 mm (*opcjonalnie: 10x/22 mm ze skalą, 12,5x/14; 15x/15; 20x/12; 25x/9)</td></tr><tr><td>Soczewki obiektywowe</td><td>planarno-achromatyczne z korekcją do nieskończoności: 4x/0,1; 10x/0,25; 40x/0,65; 100x/1,25 (olejek immersyjny); odległość parafokalna: 45 mm (*opcjonalnie: 20x/0,4; 60хs/0,80)</td></tr><tr><td>Rewolwer</td><td>5 obiektywów</td></tr><tr><td>Odległość robocza, mm</td><td>21 (4x); 5 (10x); 0,66 (40xs); 0,36 (100xs); 8,8 (20x); 0,465 (60xs)</td></tr><tr><td>Rozstaw źrenic, mm</td><td>48 — 75</td></tr><tr><td>Stolik, mm</td><td>180x150</td></tr><tr><td>Zakres ruchu stolika, z użyciem mechanizmu ustawiania ostrości, mm</td><td>75/50</td></tr><tr><td>Stolik, mm</td><td>dwuosiowy stolik mechaniczny, bez mechanizmu zapadkowego pozycjonowania osi</td></tr><tr><td>Regulacja dioptrii okularu, dioptrii</td><td>±5 (w lewej tubie)</td></tr><tr><td>Kondensor</td><td>kondensor Abbego, N.A. 1,25, regulacja centralna, regulacja wysokości, regulowana przysłona aperturowa, gniazdo suwaka ciemnego pola i suwaka kontrastu fazowego, mocowanie płetwowe</td></tr><tr><td>Diafragma</td><td>regulowana przysłona aperturowa, regulowana przysłona irysowa pola</td></tr><tr><td>Regulacja ostrości</td><td>współosiowy, zgrubna regulacja ostrości (21 mm, 39,8 mm/obrót, z pokrętłem blokady i pokrętłem regulacji napięcia) i precyzyjna regulacja ostrości (0,002 mm)</td></tr><tr><td>Oświetlenie</td><td>LED</td></tr><tr><td>Regulacja jasności</td><td>yes</td></tr><tr><td>Zasilanie</td><td>220±22 V, 50 Hz, zasilanie sieciowe AC</td></tr><tr><td>Typ źródła oświetlenia</td><td>3 W LED</td></tr><tr><td>Filtry</td><td>tak</td></tr><tr><td>Zakres temperatur, °C</td><td>5 — 35</td></tr><tr><td>Możliwość podłączenia dodatkowych urządzeń</td><td>urządzenie do kontrastu fazowego (kondensor i obiektywy), kondensor ciemnego pola (obserwacje metodą suchą i olejku immersyjnego), urządzenia do polaryzacji (polaryzator i analizator)</td></tr><tr><td>Poziom zaawansowania</td><td>doświadczeni użytkownicy, profesjonaliści</td></tr><tr><td>Poziom trudności składania i montażu</td><td>skomplikowane</td></tr><tr><td>Zastosowanie</td><td>kliniczne/laboratoryjne</td></tr><tr><td>Umiejscowienie źródła oświetlenia</td><td>dolne</td></tr><tr><td>Metoda badania</td><td>jasnego pola</td></tr><tr><td>Pokrowiec/futerał/torba w zestawie</td><td>osłona przeciwkurzowa</td></tr><tr><td>Masa, kg</td><td>8</td></tr><tr><td>Wymiary, mm</td><td>200x436x400</td></tr><tr><td>Głowica</td><td>głowica typu gemel (Siedentopf, obracana w zakresie 360°)</td></tr></tbody></table>
![[{[item.product.name]}]]([{[item.product.photo.url]}] 75w)